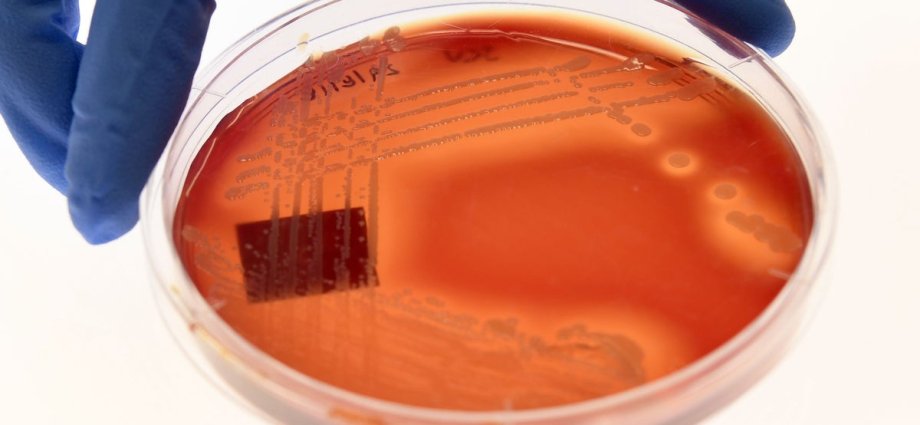

The growing global health crisis of superbug infections could undo decades of progress in medicine, according to a new report, which warns that foreign aid cuts could lead to millions more dying worldwide by 2050.
Without collective global action, growing cases of infections caused by such antimicrobial-resistant (AMR) microbes could cost the global economy nearly $2 trillion (£1.5 trillion), the UK government-funded research says.
The research forecasts the future impact of AMR on global economies under different scenarios of interventions across regions, income groups, and countries.
Bacteria have been evolving resistance to the antibiotics used by doctors to kill them in recent years, causing even what used to be the simplest-to-treat infections to become potentially life-threatening.
With scientists locked in a race to create and improve access to a “new generation” of drugs capable of defeating even the most resistant of such superbugs, global research funding cuts risk stalling progress.
If the superbug spread continued at the same trend as seen since 1990 in a “business-as-usual” scenario, it could lead to nearly 39 million deaths between 2025 and 2050, a growing body of studies suggests.

However, if there is improved access to antibiotics against such bacterial infections, it could avert 90 million deaths over this period, the latest report estimates.
Better access to antibiotics could lead to a $19bn annual reduction in healthcare costs by 2050, they say.
“This scenario would increase global GDP by $269bn over the business-as-usual scenario. The health benefits from this intervention would be worth half a billion dollars if disability-adjusted life years are valued at the GDP per capita of a given country,” scientists noted.
In comparison, the worst-case scenario of an accelerated rise in AMR at the rate of the bottom 15 per cent of countries could lead to an additional 6.7 million people dying from infections, they warn.
“Without effective interventions, healthcare costs could increase by $176bn per year by 2050, and global output could be $1.7 trillion lower than in the business-as-usual scenario,” researchers noted.
The report comes following the UK government’s Thursday announcement that it was axing the Fleming Fund – a major £265m British programme combating AMR in developing countries.
“This is a ‘stitch in time saves nine’ kind of scenario where by being proactive we can create a stronger system than if we wait for it to further decline,” health economist and lead author of the report, Anthony McDonnell, told The Independent.
“The investment needed now to lead to a better world where AMR gets better is in the order of $60bn to $70bn a year, which is a lot of money – but by 2050, the returns on this investment will be something like $1.6tn. And that is 28 times greater than the cost of action,” Dr McDonnell explained.
Previous research suggests that combating superbugs would require six to 15 new drugs developed for treatment per decade.
Scientists estimate this could require an annual additional research and development cost of $2.2bn.
“If all high-income countries funded this research and development in proportion to their GDP, it would cost them 0.0036 per cent of GDP in 2025,” they wrote.
“For these new drugs to provide the promised health benefits, people across the world must have access to them. We estimate that it would cost $59bn to ensure that all countries have outcomes for bacterial infections that match the quality of treatment currently available in the 85th percentile of countries,” researchers noted.
Considering these economic and health benefits, scientists say there would be “excellent value for money” offered by these global interventions.
“It is in high-income countries’ interests to fund particularly low-income countries to improve their health systems even in just like a purely selfish way, so the axing of the Fleming Fund is very unfortunate,” Dr McDonnell said.
“If the US, and indeed the UK, Germany and France are not going to be reliable as countries once thought, then I think it only makes sense for low-and middle-income countries who have relied on them for aid to be more careful,” he added.
This article is part of The Independent’s Rethinking Global Aid project